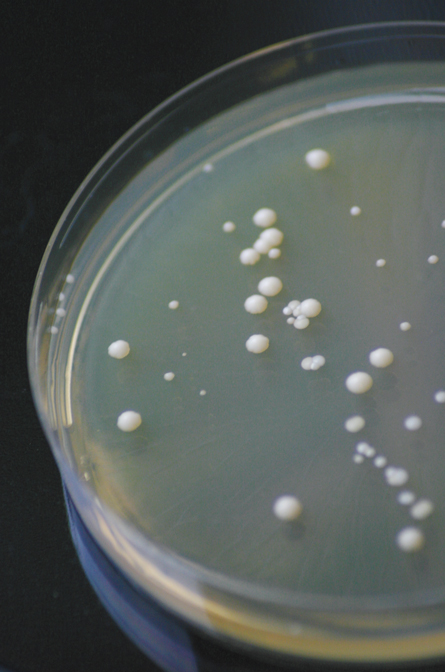

Cheaters may not only prosper, they can make life better for everyone else too, a new study of cooperation in yeast reveals.
Common wisdom and scientific research on cooperation agree that the world is a much better place when everyone pulls their own weight, says Laurence Hurst, an evolutionary systems biologist at the University of Bath in England and a coauthor of the new study. That notion, known as the conspiracy of doves, has “largely gone untested because it was so obviously right,” he says.
But the long-held assumption that too many slackers spoil the broth for everyone turns out not to be true in all cases. In a new study published September 14 in PLoS Biology, Hurst and his colleagues show that mixed communities of hard-working yeast and loafers can outgrow cultures in which all yeast contribute equally.
In the new study, yeast cultures were grown in broth containing sucrose as a sugar source. To eat sucrose, yeast first have to slice the sucrose molecule into more easily digestible glucose and fructose molecules with an enzyme called invertase.
In wild populations, invertase-making yeast live side-by-side with yeast that don’t make the enzyme and so must rely on the invertase-makers to cut up the food. Most models of cooperation would predict that mixed cultures of invertase-making “cooperator” yeast and nonproducing “cheaters” would not fare as well as communities of enzyme-producing yeast alone. But when study coauthors R. Craig MacLean of the University of Oxford and Duncan Greig of University College London and the Max Planck Institute for Evolutionary Biology in Plön, Germany, grew cultures of the two types of yeast, flasks containing a mix of cooperator and cheater yeast grew faster and denser than ones with invertase-making yeast alone. The result had the researchers scratching their heads and asking, “How can this be?” says Ivana Gudelj, a mathematical systems biologist at Imperial College London.
Gudelj and postgraduate student Ayari Fuentes-Hernandez created a mathematical model that explains the puzzling result. The seemingly freeloading yeast in the mixed cultures actually help their enzyme-producing counterparts use sucrose more efficiently by indirectly slowing its conversion to glucose, the researchers found.
This is important because yeast use levels of glucose, not sucrose, as a way to control how much invertase is produced. So, on their own, enzyme-producing yeast make a lot of invertase and quickly burn through their food supply, limiting growth. By taking up any extra glucose, cheater yeast help the other yeast limit expensive invertase production, which forces more efficient use of sucrose and slower, but steadier, growth.
The model predicts that cheaters can be helpful when three conditions apply: resources are squandered when abundant, organisms can’t predict the amount of cooperation needed and cooperators get a greater share of the resources than cheaters do. Those conditions probably apply to a variety of real-world situations, the researchers say.
“I think this is a useful experiment,” says Laurent Keller, an evolutionary biologist at the University of Lausanne in Switzerland who was not involved with the research. Most studies of cooperation are conducted under more restricted laboratory conditions, he says, which may not bear much resemblance to ever-changing natural conditions.
The new study shows that changing environmental conditions can alter the way organisms interact with each other, perhaps even turning a cheater into a cooperator in certain circumstances, he says. “This interaction can be more complex than what people think.”
For example, the researchers showed that in unshaken flasks, glucose doesn’t diffuse far from enzyme-making yeast so cooperators get a bigger spoonful of sugar than nonproducers do. When flasks are shaken so that glucose is more evenly distributed, the benefit of having cheaters around is lost.